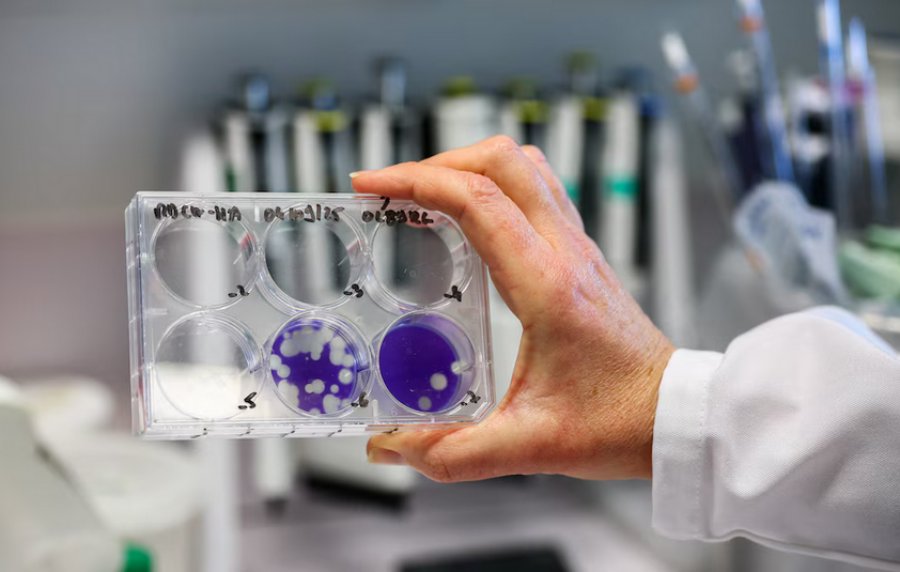
La Administración Nacional de Laboratorios e Institutos de Salud (ANLIS) “Dr. Carlos G. Malbrán”  detectó tres casos de influenza A (H3N2) subclado K en Argentina

Infobae pudo saber que el hallazgo corresponde a dos adolescentes en Santa Cruz y un niño en la Ciudad Autónoma de Buenos Aires, todos con evolución favorable y sin complicaciones clínicas reportadas.
La Administración Nacional de Laboratorios e Institutos de Salud (ANLIS) “Dr. Carlos G. Malbrán” en la Ciudad Autónoma de Buenos Aires (CABA) confirmó la detección de tres casos de influenza A(H3N2) del subclado K en Argentina. Según pudo saber Infobae, los casos corresponden a dos adolescentes de la provincia de Santa Cruz y a un niño internado en la Ciudad Autónoma de Buenos Aires, todos sin complicaciones clínicas.
La vigilancia epidemiológica se mantiene activa y dentro de los valores esperados para la época, de acuerdo con la información del organismo de diagnóstico referencial e investigación de enfermedades infecciosas.
La Administración Nacional de Laboratorios e Institutos de Salud (ANLIS) “Dr. Carlos G. Malbrán” confirmó la detección de tres casos de influenza A(H3N2) del subclado K en Argentina. Según pudo saber Infobae, los casos corresponden a dos adolescentes de la provincia de Santa Cruz y a un niño internado en la Ciudad Autónoma de Buenos Aires, todos sin complicaciones clínicas.
La vigilancia epidemiológica se mantiene activa y dentro de los valores esperados para la época, de acuerdo con la información del organismo de diagnóstico referencial e investigación de enfermedades infecciosas.
La detección se realizó a través de la Red Nacional de Laboratorios y Unidades Centinela, con confirmación del Laboratorio Nacional de Referencia del INEI-ANLIS mediante secuenciación genómica. Este análisis permitió clasificar los virus dentro del subclado K, que presenta cambios genéticos asociados a una mayor transmisibilidad.

ANLIS Malbrán destaca el monitoreo activo de virus respiratorios en todas las provincias argentinas
Según ANLIS “Dr. Carlos G. Malbrán”, la evidencia disponible hasta el momento no indica que este subclado cause cuadros clínicos más graves en comparación con otros virus de influenza A(H3N2) detectados en temporadas anteriores.
En relación con el estado de los pacientes, los tres afectados atravesaron la enfermedad sin complicaciones. De acuerdo con la misma información oficial, el caso del niño en la Ciudad Autónoma de Buenos Aires requirió internación, mientras que los adolescentes de Santa Cruz fueron estudiados en el marco del Monitoreo Ambulatorio de Infecciones Respiratorias Agudas. Las autoridades sanitarias provinciales tienen la responsabilidad de investigar cada caso y garantizar la atención oportuna, en coordinación con la vigilancia nacional.
El monitoreo de la circulación viral en el país, que abarca tanto influenza como otros virus respiratorios, se mantiene dentro de los parámetros habituales para el periodo, subrayó la información surgida del ANLIS “Dr. Carlos G. Malbrán”. Esa institución y la Dirección de Epidemiología del Ministerio de Salud de la Nación están acompañando el trabajo de vigilancia en las 24 jurisdicciones del país, con el objetivo de identificar oportunamente cualquier cambio en los patrones de transmisión, severidad o en las características de las poblaciones afectadas.
Entre las recomendaciones oficiales, se destaca la importancia de que las personas con síntomas respiratorios compatibles con infección viral consulten al sistema de salud de su jurisdicción, especialmente quienes integran grupos de riesgo. El llamado busca reforzar la detección temprana y la atención oportuna ante la circulación de este y otros virus respiratorios.
En línea con su función, ANLIS “Dr. Carlos G. Malbrán” continuará aportando información técnica y evidencia científica al sistema sanitario nacional, contribuyendo a una respuesta basada en datos frente a la dinámica de los virus respiratorios en Argentina.
Como adelantó Infobae, la circulación de una nueva subvariante del virus de la influenza A, conocida como subclado K de la gripe H3N2, encendió alertas sanitarias en distintos puntos del planeta y comenzó a impactar también en América del Sur.
Identificada primero en Asia y luego extendida a Europa y América del Norte, esta variante mostró una capacidad de transmisión superior a la de otras cepas estacionales, lo que motivó un refuerzo de la vigilancia epidemiológica en países de la región ante la posibilidad de nuevos casos importados. En los últimos días, Perú, Chile y Bolivia ya confirmaron los primeros contagios vinculados al subclado K.

La higiene frecuente de manos y el lavado adecuado con agua y jabón son medidas esenciales recomendadas para prevenir la transmisión de la influenza y otros virus respiratorios (Freepik)
El infectólogo Ricardo Teijeiro remarcó a Infobae que sin duda esta variante de la gripe va a llegar al país a través de algún viajero contagiado.
“Eso no quiere decir que haya riesgo en el hemisferio sur a modo de brote. Para que eso suceda, se necesitan algunas características como el estar hacinado, en grupos encerrados en lugares sin ventilación, tener secreciones respiratorias, entre otros”.
“Este subclado está asociado a una mayor transmisibilidad pero que, según la evidencia disponible al momento, no se asocia a una mayor gravedad en comparación con otros virus de influenza A que han circulado en temporadas previas. Es muy importante que las personas embarazadas y puérperas, las y los niños de 6 a 24 meses, las personas mayores de 65, las personas con factores de riesgo y el personal de salud tengan la vacuna antigripal 2025 aplicada”, remarcó por su parte en su cuenta de X, Nicolás Kreplak, ministro de Salud de la Provincia de Buenos Aires.
Subclado K: por qué preocupa a los sistemas de salud
La gripe H3N2 es una variante del virus de la influenza A, uno de los tipos más comunes que circulan cada año a nivel mundial. Se transmite principalmente a través de gotitas respiratorias expulsadas al hablar, toser o estornudar, así como por el contacto con superficies contaminadas y el posterior contacto con la nariz, la boca o los ojos. Sus síntomas suelen aparecer de manera brusca e incluyen fiebre alta, dolor muscular, tos seca, dolor de garganta y un marcado cansancio.

El fortalecimiento del sistema de laboratorios centinela hace posible identificar mutaciones virales relevantes (Canva)
El subclado K, denominado técnicamente J.2.4.1, representa una evolución genética del subtipo H3N2. Se trata de una variante de gripe estacional particularmente contagiosa, aunque no más grave que otras cepas conocidas.
Su mayor transmisibilidad se vincula a mutaciones en la hemaglutinina, una molécula clave que permite al virus ingresar en las células humanas. Estos cambios facilitan la propagación del virus incluso en poblaciones con cierto grado de inmunidad previa.
Los síntomas asociados al subclado K no difieren de los habituales de la gripe estacional.
La fiebre alta suele superar los 38 grados y aparece de forma repentina, acompañada de escalofríos, malestar general y una intensa sensación de cansancio. El dolor muscular y articular afecta con frecuencia a piernas, espalda y brazos, y puede dificultar las actividades cotidianas. El dolor de cabeza persistente, la tos seca y la congestión nasal completan el cuadro clínico más común.
Por Daniela Blanco

Es Directora Editorial en Infobae. Licenciada en Ciencias de la Comunicación (UBA). Periodista desde hace más de 20 años en medios nacionales e internacionales. Integra el consejo asesor de WINN (Women in the News Network) la red de periodistas mujeres de Hispanoamérica. Profesora universitaria, académica y conferencista en temas de comunicación y sociedad.
Foto.- Portada - Reuters/Gonzalo Fuentes - Los casos confirmados en adolescentes de Santa Cruz y un niño de Buenos Aires evolucionaron favorablemente sin complicaciones graves
Fuente.- https://www.infobae.com/